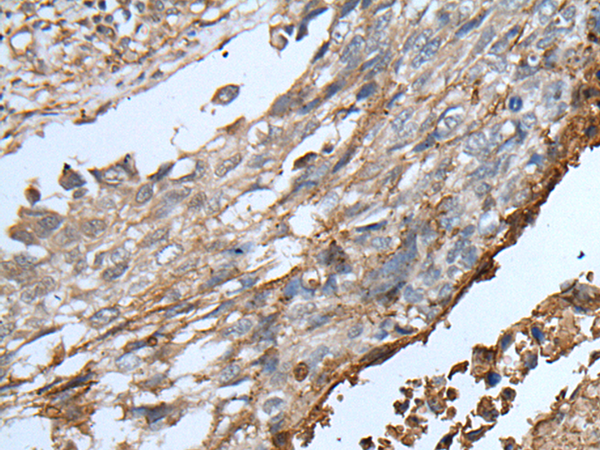

-
分类: 科研抗体货号: P05936别名: P500; SISe; TCA3; I-309; SCYA1应用: WB反应种属: Human
-
分类: 科研抗体货号: P05889别名: SAR1; p195; HUMORFA01应用: WB,IHC反应种属: Human, Mouse
-
分类: 科研抗体货号: P05985别名: HCNP; HCRN; SYF1; NTC90应用: WB,IHC反应种属: Human, Mouse, Rat
-
分类: 科研抗体货号: P05931别名: EBN2; BFNC2; KV7.3应用: IHC反应种属: Human, Mouse, Rat
-
分类: 科研抗体货号: P05886别名: IL6Q; gp80; CD126; IL6RA; IL6RQ; IL-6RA; IL-6R-1应用: IHC反应种属: Human
-
分类: 科研抗体货号: P05984别名: ZNF631应用: IHC反应种属: Human
-
分类: 科研抗体货号: P05928别名: KLR; CD314; NKG2D; NKG2-D; D12S2489E应用: WB,IHC反应种属: Human, Mouse, Rat
-
分类: 科研抗体货号: P05885别名: CT119; VSIG3; Igsf13; BT-IgSF; CXADRL1应用: IHC反应种属: Human
-
分类: 科研抗体货号: P05975别名: VGL3; VGL-3应用: IHC反应种属: Human, Mouse
-
分类: 科研抗体货号: P05927别名: PICK; PRKCABP应用: WB反应种属: Human, Mouse, Rat

鄂公网安备42018502007531号
鄂公网安备42018502007531号

